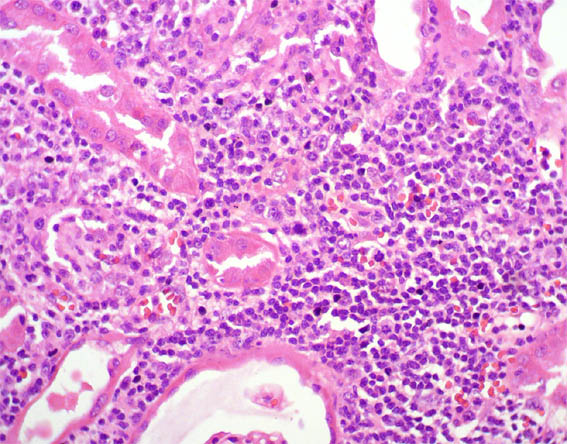

CASE
96 (February 2014)
Clinical information
The patient is a 34-year-old woman with terminal renal failure of unknown cause. After four months on hemodialysis is transplanted with a kidney from a deceased donor. Very good initial renal function, discharged the sixth post-transplant day with serum creatinine 1.1 mg/dL.
Subsequent controls with normal renal function until the fourth post-transplant month when creatinine increased to 2.3 mg/dL. She was scheduled for renal biopsy guided by ultrasound, but in the echography the lower half of the graft appear markedly enlarged with mass appearance and apparent compression of the renal hilum.
A renal open biopsy was performed. See the images:

Figure 1. H&E, X40.

Figure 2.
H&E, X100.

Figure 3. H&E, X200.

Figure 4. H&E, X400.
Figure 5. H&E, X400.

Figure 6. H&E, X400.

Figure 7. PAS, X400.

Figure 8. Methenamine-silver stain, X400.

Figure 9. Immunohistochemistry for CD3, X400.

Figure 10. Immunohistochemistry for CD20, X400.

Figure 11. Immunohistochemistry for CD30, X400.

Figure 12. Immunohistochemistry for CD38, X400.

Figure 13. Immunohistochemistry for Ki67, X400.

Figure 14. In situ hibridization for Epstein-Barr (EBER), X400.
What is your diagnosis?
See
diagnosis and discussion
[Top]
|